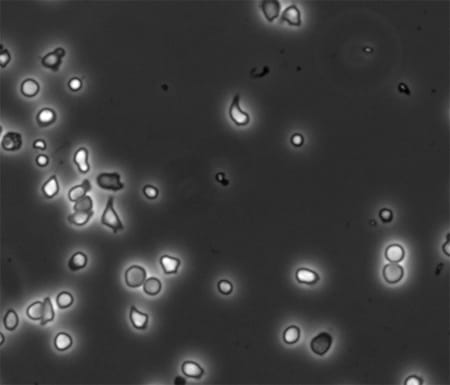
Neutrophil migration.

Mechanism of neutrophil migration
Neutrophils are the most abundant white blood cell in humans, and form the body’s first line of cellular defense against infecting microorganisms. While normally found in the blood stream, neutrophils migrate rapidly to sites of infection in tissue. The neutrophils trans-endothelial migration (TEM) process can occur by migration of neutrophils either directly through individual endothelial cells (the transcellular route) or between them (the paracellular route). This migration is tightly regulated; indeed, aberrant accumulation of neutrophils and subsequent reactive oxygen species (ROS) release causes tissue injury, in particular acute lung injury (ALI) and acute respiratory distress syndrome (ARDS), and cancer.
Our laboratory focuses on dissecting the molecular regulation of neutrophil migration to specific tissue inflammation sites in order to provide rationale to devise novel therapeutic approaches to neutrophil mediated inflammation. We have made major contribution to the field by identifying Cdc42 as a critical regulator of neutrophil polarity via integrin signaling. The current goals of this program research are to identify Cdc42 effectors that are important for neutrophil migration and dissect their roles in transcellular versus paracellular route. We are using proteomics and biochemistry assays, knock out animal models, state of the art microscopy techniques, including live cell imaging and immunofluorescence / deconvolution analysis, as well as in vivo mouse models of lung inflammation.
This work is highly significant in many ways. Integrin dysfunctions have been described in various forms of leukocyte adhesion deficiency in humans leading to severe neutrophil-associated immunodeficiency. The Cdc42 effector WASp is mutated in human that leads to an immunodeficiency syndrome also associated with neutrophil defects. Neutrophils are critical effector cells of inflammation. Therefore, our work will have important physiological and pathophysiological implications of immunodeficiency and inflammation disorders.